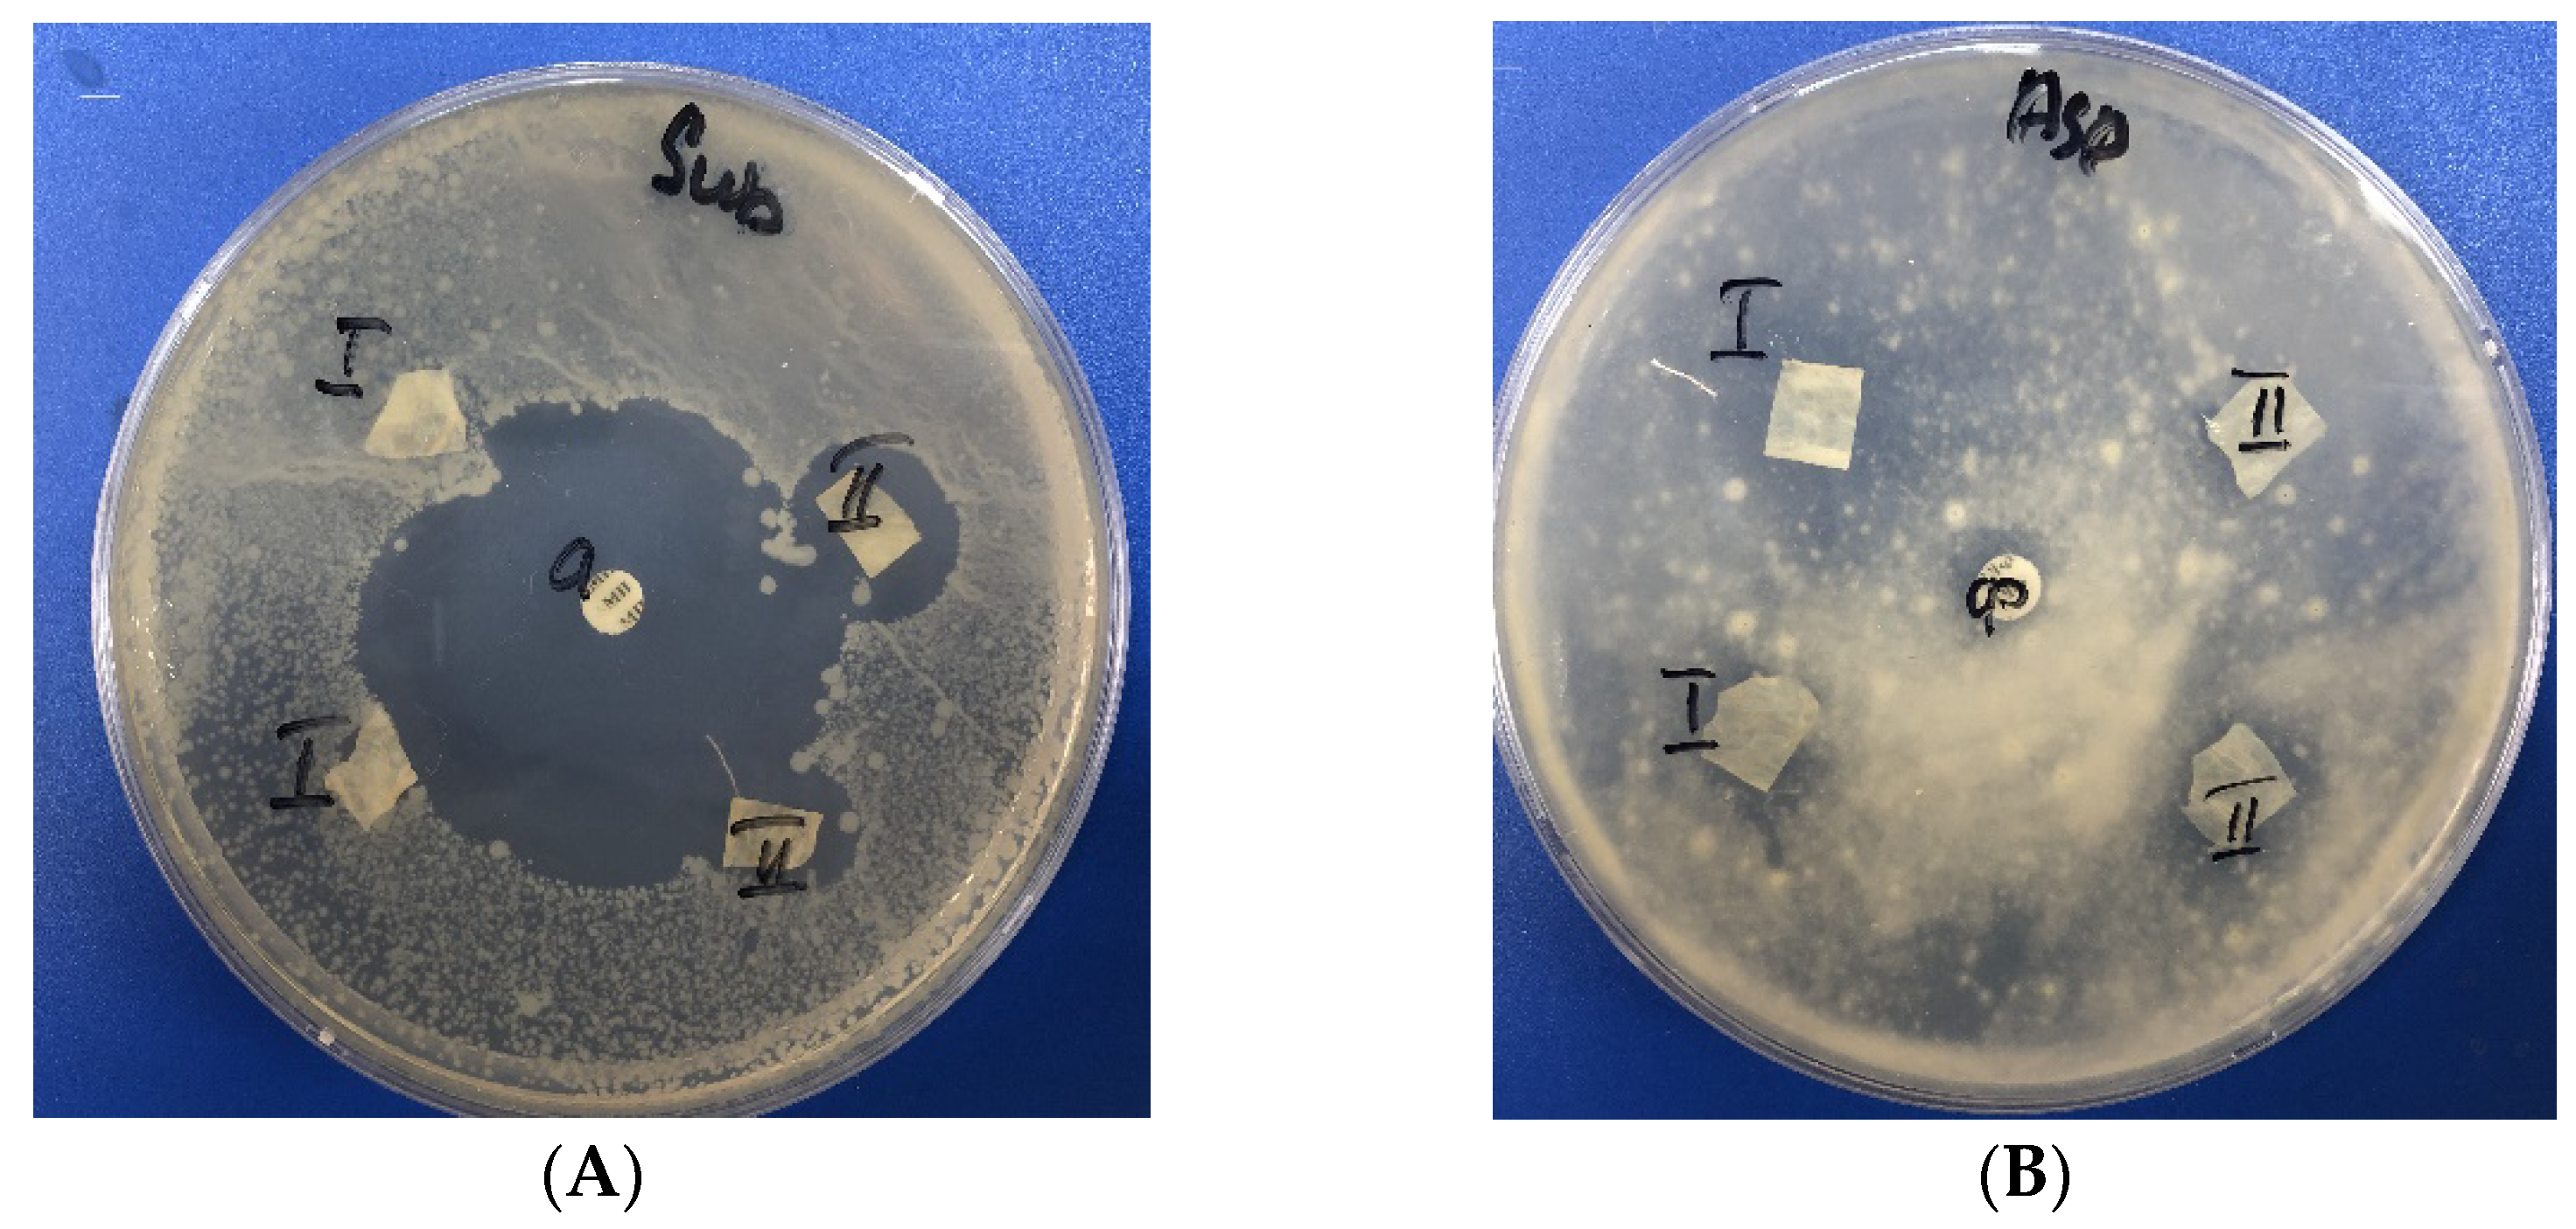
Polymers 14 03907 g008

Effect of Bacterial Cellulose Plasma Treatment on the Biological Activity of Ag Nanoparticles Deposited Using Magnetron Deposition
Abstract
:1. Introduction
2. Materials and Methods
2.1. Production and Characterization of Bacterial Cellulose
2.2. Modification of BC Surface by Plasma Treatment
2.3. Metallization of BC Surface by Magnetron Sputtering
2.4. Scanning Electron Microscopy
2.5. Transmission Electron Microscopy
2.6. X-ray Photoelectron Spectroscopy
2.7. Antimicrobial Activity Assay
3. Results and Discussion
4. Conclusions
Author Contributions
Funding
Institutional Review Board Statement
Data Availability Statement
Conflicts of Interest
References
- Moniri, M.; Boroumand, M.A.; Azizi, S.; Abdul, R.R.; Bin Ariff, A.; Zuhainis, S.W.; Navaderi, M.; Mohamad, R. Production and status of bacterial cellulose in biomedical engineering. Nanomaterials 2017, 7, 257. [Google Scholar] [CrossRef] [PubMed]
- Han, Y.-H.; Mao, H.-L.; Wang, S.-S.; Deng, J.-C.; Chen, D.-L.; Li, M. Ecofriendly green biosynthesis of bacterial cellulose by Komagataeibacter xylinus B2-1 using the shell extract of Sapindus mukorossi Gaertn. as culture medium. Cellulose 2019, 27, 1255–1272. [Google Scholar] [CrossRef]
- Tsouko, E.; Maina, S.; Ladakis, D.; Kookos, I.K.; Koutinas, A. Integrated biorefinery development for the extraction of value-added components and bacterial cellulose production from orange peel waste streams. Renew. Energy 2020, 160, 944–954. [Google Scholar] [CrossRef]
- Liu, W.; Du, H.; Zhang, M.; Liu, K.; Liu, H.; Xie, H.; Zhang, X.; Si, C. Bacterial Cellulose-Based Composite Scaffolds for Biomedical Applications: A Review. ACS Sustain. Chem. Eng. 2020, 8, 7536–7562. [Google Scholar] [CrossRef]
- Tseomashko, N.E.; Rai, M.; Vasil’kov, A.Y. New hybrid materials for wound cover dressings. In Bio-Polymer-Based Nano Films; Rai, M., Dos Santos, C.A., Eds.; Elsevier Inc.: Cambridge, MA, USA, 2021; pp. 203–245. [Google Scholar] [CrossRef]
- Pruskowski, K.A.; Mitchell, T.A.; Kiley, J.L.; Wellington, T.; Britton, G.W.; Cancio, L.C. Diagnosis and Management of Invasive Fungal Wound Infections in Burn Patients. Eur. Burn J. 2021, 2, 168–183. [Google Scholar] [CrossRef]
- Aries, P.; Hoffmann, C.; Schaal, J.-V.; Leclerc, T.; Donat, N.; Cirodde, A.; Masson, Y.; Renner, J.; Soler, C. Aspergillus tamarii: An uncommon burn wound infection. J. Clin. Pathol. 2018, 71, 379–380. [Google Scholar] [CrossRef]
- Struck, M.F.; Gille, J. Fungal infection in burns: Acomprehensive reviwer. Ann. Burn. Fire Disasters 2013, 26, 147–153. [Google Scholar]
- Zhang, Z.-Y.; Sun, Y.; Zheng, Y.-D.; He, W.; Yang, Y.-Y.; Xie, Y.-J.; Feng, Z.-X.; Qiao, K. A biocompatible bacterial cellulose/tannic acid composite with antibacterial and anti-biofilm activities for biomedical applications. Mater. Sci. Eng. C. 2020, 106, 110249. [Google Scholar] [CrossRef]
- Gromovykh, T.I.; Vasil’kov AYu Sadykova, V.S.; Feldman, N.B.; Demchenko, A.G.; Lyundup, A.V.; Butenko, I.E.; Lutsenko, S.V. Creation of composites of bacterial cellulose and silver nanoparticles: Evaluation of antimicrobial activity and cytotoxicity. Int. J. Nanotechnol. 2019, 16, 408–420. [Google Scholar] [CrossRef]
- Volova, T.; Shumilova, A.; Shidlovsky, I.; Nikolaeva, E.; Sukovatiy, A.; Vasilieva, A.; Shishatskaya, E. Antibacterial properties of films of cellulose composites with silver nanoparticles and antibiotics. Polym. Test. 2018, 65, 54–68. [Google Scholar] [CrossRef] [Green Version]
- He, W.; Huang, X.; Zheng, Y.; Sun, Y.; Xie, Y.; Wang, Y.; Yue, L. In situ synthesis of bacterial cellulose/copper nanoparticles composite membranes with long term antibacterial property. J. Biomater. Sci. Polym. Ed. 2018, 29, 2137–2153. [Google Scholar] [CrossRef]
- Mocanu, A.; Isopencu, G.; Busuioc, C.; Popa, O.-M.; Dietrich, P.; Socaciu-Siebert, L. Bacterial cellulose films with ZnO nanoparticles and propolis extracts: Synergistic antimicrobial effect. Sci. Rep. 2019, 9, 17687. [Google Scholar] [CrossRef]
- Malmira, S.; Karbalaeia, A.; Pourmadadip, M.; Hamedid, I.; Yazdianc, F.; Navaeef, M. Antibacterial properties of a bacterial cellulose CQD-TiO2 nanocomposite. Carbohydr. Polym. 2020, 234, 115835. [Google Scholar] [CrossRef]
- Peterson, E.; Kaur, P. Antibiotic Resistance Mechanisms in Bacteria: Relationships Between Resistance Determinants of Antibiotic Producers, Environmental Bacteria, and Clinical Pathogens. Front. Microbiol. 2018, 9, 2928. [Google Scholar] [CrossRef]
- Benetti, G.; Cavaliere, E.; Banfi, F.; Gavioli, L. Antimicrobial nanostructured coatings: A gas phase deposition and magnetron sputtering perspective. Materials 2020, 13, 784. [Google Scholar] [CrossRef]
- Azizi-Lalabadi, M.; Garavand, F.; Jafari, S.M. Incorporation of silver nanoparticles into active antimicrobial nanocomposites: Release behavior, analyzing techniques, applications and safety issues. Adv. Colloid Interface Sci. 2021, 293, 102440. [Google Scholar] [CrossRef]
- Khan, S.; Ul-Islam, M.; Ullah, M.W.; Zhu, Y.; Narayanan, K.B.; Han, S.S.; Park, J.K. Fabrication strategies and biomedical applications of three-dimensional bacterial cellulose-based scaffolds: A review. Int. J. Biol. Macromol. 2022, 209, 9–30. [Google Scholar] [CrossRef]
- Popa, L.; Ghica, M.V.; Tudoroiu, E.E.; Ionescu, D.G.; Dinu-Pîrvu, C.E. Bacterial Cellulose—A Remarkable Polymer as a Source for Biomaterials Tailoring. Materials 2022, 15, 1054. [Google Scholar] [CrossRef]
- Radetić, M.; Marković, D. A review on the role of plasma technology in the nano-finishing of textile materials with metal and metal oxide nanoparticles. Plasma Process. Polym. 2022, 19, 2100197. [Google Scholar] [CrossRef]
- Dallas, P.; Sharma, V.K.; Zboril, R. Silver polymeric nanocomposites as advanced antimicrobial agents: Classification, synthetic paths, applications, and perspectives. Adv. Colloid Interface Sci. 2011, 166, 119–135. [Google Scholar] [CrossRef]
- Mejía, M.I.; Restrepo, G.; Marín, J.M.; Sanjines, R.; Pulgarín, C.; Mielczarski, E.; Mielczarski, J.; Kiwi, J. Magnetron-sputtered Ag surfaces. New evidence for the nature of the Ag ions intervening in bacterial inactivation. ACS Appl. Mater. Interfaces 2010, 2, 230–235. [Google Scholar] [CrossRef] [PubMed]
- Katouah, H.; El-Metwaly, N.M. Plasma treatment toward electrically conductive and superhydrophobic cotton fibers by in situ preparation of polypyrrole and silver nanoparticles. React. Funct. Polym. 2021, 159, 104810. [Google Scholar] [CrossRef]
- Atta, A.M.; Abomelka, H.M. Multifunctional finishing of cotton fibers using silver nanoparticles via microwave-assisted reduction of silver alkylcarbamate. Mater. Chem. Phys. 2021, 260, 124137. [Google Scholar] [CrossRef]
- Yang, G.; Xie, J.; Deng, Y.; Bian, Y.; Hong, F. Hydrothermal synthesis of bacterial cellulose/AgNPs composite: A “green” route for antibacterial application. Carbohydr. Polym. 2012, 87, 2482–2487. [Google Scholar] [CrossRef]
- Zahoor, M.; Nazir, N.; Iftikhar, M.; Naz, S.; Zekker, I.; Burlakovs, J. Faheem Uddin Abdul Waheed Kamran AKallistova NPimenov Ali Khan, F. A review on silver nanoparticles: Classification, various methods of synthesis, and their potential roles in biomedical applications and water treatment. Water 2021, 13, 2216. [Google Scholar] [CrossRef]
- Shalia, T.; Sudarsan, N. Tailoring the Adhesion of Polymers using Plasma for Biomedical Applications: A Critical Review. Rev. Adhes. Adhes. 2015, 3, 53–97. [Google Scholar]
- Pertile, R.; Andrade, F.; Alves, C.; Gama, M. Surface modification of bacterial cellulose by nitrogen-containing plasma for improved interaction with cells. Carbohydr. Polym. 2010, 82, 692–698. [Google Scholar] [CrossRef]
- Bhanthumnavin, W.; Wanichapichart, P.; Taweepreeda, W.; Sirijarukula, S.; Paosawatyanyong, B. Surface modification of bacterial cellulose membrane by oxygen plasma treatment. Surf. Coat. Technol. 2016, 306, 272–278. [Google Scholar] [CrossRef]
- Wei, P.; Lou, H.; Xu, X.; Xu, W.; Yang, H.; Zhang, W.; Zhang, Y. Preparation of PP non-woven fabric with good heavy metal adsorption performance via plasma modification and graft polymerization. Appl. Surf. Sci. 2021, 539, 148195. [Google Scholar] [CrossRef]
- Learn, G.; Lai, E.; von Recum, H. Nonthermal Plasma Treatment Improves Uniformity and Adherence of Cyclodextrin-Based Coatings on Hydrophobic Polymer Substrates. Coatings 2020, 10, 1056. [Google Scholar] [CrossRef]
- Gama, L.; Duque, T.; Özcan, M.; Philippi, A.; Mezzomo, L.; Gonçalves, T. Adhesion to high-performance polymers applied in dentistry: A systematic review. Dent. Mater. 2020, 36, e93–e108. [Google Scholar] [CrossRef]
- Haji, A.; Naebe, M. Cleaner dyeing of textiles using plasma treatment and natural dyes: A review. J. Clean. Prod. 2020, 265, 121866. [Google Scholar] [CrossRef]
- Lv, P.; Xu, W.; Li, D.; Feng, Q.; Yao, Y.; Pang, Z.; Lucia, L.; Wei, Q. Metal-based bacterial cellulose of sandwich nanomaterials for anti-oxidation electromagnetic interference shielding. Mater. Des. 2016, 112, 374–382. [Google Scholar] [CrossRef]
- Vosmanska, V.; Kolarova, K.; Rimpelova, S.; Svorcik, V. Surface modification of oxidized cellulose haemostat by argon plasma treatment. Cellulose 2014, 21, 2445–2456. [Google Scholar] [CrossRef]
- Ribeiro, A.I.; Senturk, D.; Silva, K.S.; Modic, M.; Cvelbar, U.; Dinescu, G.; Mitu, B.; Nikiforov, A.; Leys, C.; Kuchakova, I.; et al. Efficient silver nanoparticles deposition method on DBD plasma-treated polyamide 6,6 for antimicrobial textiles. IOP Conf. Ser. Mater. Sci. Eng. 2018, 460, 012007. [Google Scholar] [CrossRef]
- Tomsic, B.; Vasiljević, J.; Simoncic, B.; Radoičić, M.; Radetić, M. The influence of corona treatment and impregnation with colloidal TiO2 nanoparticles on biodegradability of cotton fabric. Cellulose 2017, 24, 4533–4545. [Google Scholar] [CrossRef]
- Irfan, M.; Perero, S.; Miola, M.; Maina, G.; Ferri, A.; Ferraris, M.; Balagna, C. Antimicrobial functionalization of cotton fabric with silver nanoclusters/silica composite coating via RF co-sputtering technique. Cellulose 2017, 24, 2331–2345. [Google Scholar] [CrossRef]
- Olenin, A.; Lisichkin, G. Metal nanoparticles in condensed media: Preparation and the bulk and surface structural dynamics. Russ. Chem. Rev. 2011, 80, 605–630. [Google Scholar] [CrossRef]
- Gromovykh, T.; Phan, M.; Danil’chuk, T. Gluconacetobacter Hansenii GH1/2008 Bacterial Strain—Bacterial Cellulose Producer. RF Patent 2464307, 20 October 2012. [Google Scholar]
- Gromovykh, T.; Lutcenko, S.; Feldman, N.; Kashirin, V.; Sadykova, V.; Dmitrenok, A.; Kashirin, V. Bacterial cellulose synthesized by Gluconacetobacter hansenii for medical applications. Appl. Biochem. Microbiol. 2017, 53, 60–67. [Google Scholar] [CrossRef]
- Makarov, I.; Shambilova, G.; Vinogradov, M.; Zatonskih, P.; Gromovykh, T.; Lutsenko, S.; Arkharova, N.; Kulichikhin, V. Films of Bacterial Cellulose Prepared from Solutions in N-Methylmorpholine-N-Oxide: Structure and Properties. Processes 2020, 8, 171. [Google Scholar] [CrossRef]
- Beamson, G.; Briggs, D. High Resolution XPS of Organic Polymers: The Scienta ESCA 300 Database; Wiley: Chichester, UK, 1992; 280p. [Google Scholar] [CrossRef]
- Vasil’kov, A.Y.; Abd-Elsalam, K.A.; Olenin, A.Y. Biogenic Silver Nanoparticles: New Trends and Applications. In Nanobiotechnology for Plant Protection. Green Synthesis of Silver Nanomaterials; Abd-Elsalam, K.A., Ed.; Elsevier Inc.: Cambridge, MA, USA, 2021; pp. 241–281. [Google Scholar] [CrossRef]
- Chen, Q.-Y.; Xiao, S.-L.; Shi, S.; Cai, L.-P. A One-Pot Synthesis and Characterization of Antibacterial Silver Nanoparticle–Cellulose Film. Polymers 2020, 12, 440. [Google Scholar] [CrossRef] [PubMed]
- Pugazhendhi, A.; Prabakar, D.; Jacob, J.; Karuppusamy, I.; Saratale, R. Synthesis and characterization of silver nanoparticles using Gelidium amansii and its antimicrobial property against various pathogenic bacteria. Microb. Pathog. 2018, 114, 41–45. [Google Scholar] [CrossRef] [PubMed]
- Pal, S.; Nisi, R.; Stoppa, M.; Licciulli, A. Silver-Functionalized Bacterial Cellulose as Antibacterial Membrane for Wound-Healing Applications. ACS Omega 2017, 2, 3632–3639. [Google Scholar] [CrossRef] [PubMed]
- Hu, B.; Yin, N.; Yang, R.; Liang, S.; Liang, S.; Faiola, F. Silver nanoparticles (AgNPs) and AgNO3 perturb the specification of human hepatocyte-like cells and cardiomyocytes. Sci. Total Environ. 2020, 725, 138433. [Google Scholar] [CrossRef]
- Purniawan, A.; Hermastuti, R.; Purwaningsih, H.; Atmono, T.M. Effect of deposition time of sputtering Ag-Cu thin film on mechanical and antimicrobial properties. AIP Conf. Proc. 2018, 1945, 020008. [Google Scholar] [CrossRef]
- Elayaraja, S.; Liu, G.; Zagorsek, K.; Mabrok, M.; Ji, M.; Ye, Z.; Zhu, S.; Rodkhum, C. TEMPO-oxidized biodegradable bacterial cellulose (BBC) membrane coated with biologically-synthesized silver nanoparticles (AgNPs) as a potential antimicrobial agent in aquaculture (In vitro). Aquaculture 2021, 530, 735–746. [Google Scholar] [CrossRef]
- Aksit, A.; Camlibel, N.; Zeren, E.; Kutlu, B. Development of antibacterial fabrics by treatment with Ag-doped TiO2 nanoparticles. J. Text. Inst. 2017, 108, 2046–2056. [Google Scholar] [CrossRef]
- Leal, S.; Cristelo, C.; Silvestre, S.; Fortunato, E.; Sousa, A.; Alves, A.; Correia, D.M.; Lanceros-Mendez, S.; Gama, M. Hydrophobic modification of bacterial cellulose using oxygen plasma treatment and chemical vapor deposition. Cellulose 2020, 27, 10733–10746. [Google Scholar] [CrossRef]
- Meng, L.; Wei, Q.; Li, Y.; Xu, W. Effects of plasma pre-treatment on surface properties of fabric sputtered with copper. Int. J. Cloth. Sci. Technol. 2014, 26, 96–104. [Google Scholar] [CrossRef]
- Asanithi, P.; Chaiyakun, S.; Limsuwan, P. Growth of Silver Nanoparticles by DC Magnetron Sputtering. J. Nanomater. 2012, 2012, 963609. [Google Scholar] [CrossRef]
- Seah, M.P. AES: Energy calibration of electron spectrometers. IV. A reevaluation of the reference energies. J. Electron Spectrosc. Relat. Phenom. 1998, 97, 235–241. Available online: https://goo.gl/ekaCwB (accessed on 1 September 2022). [CrossRef]
- Moulder, J.F.; Stickle, W.F.; Sobol, P.E.; Bomben, K.D. Handbook of X-ray Photoelectron Spectroscopy; Perkin Elmer Corporation: Eden Prairie, MN, USA, 1995; 260p. [Google Scholar]
- Wang, B.-T.; Hu, S.; Yu, X.-Y.; Jin, L.; Zhu, Y.-J.; Jin, F.-J. Studies of Cellulose and Starch Utilization and the Regulatory Mechanisms of Related Enzymes in Fungi. Polymers 2020, 12, 530. [Google Scholar] [CrossRef] [Green Version]

| Sample | Group | C-C/C-H | C-OH | O-C-O | C=O | C(O)O |
|---|---|---|---|---|---|---|
| BC | Eb, eV | 285.03 | 286.73 | 288.08 | 288.56 | |
| W, eV | 0.96 | 1.04 | 1.03 | 1.20 | ||
| Irel | 0.05 | 0.75 | 0.15 | 0.05 | ||
| BCP | Eb, eV | 285.03 | 286.73 | 288.06 | 288.5 | 289.51 |
| W, eV | 1.26 | 1.09 | 1.0 | 1.15 | 1.15 | |
| Irel | 0.15 | 0.57 | 0.11 | 0.10 | 0.06 | |
| BC-Ag | Eb,eV | 285.4 | 286.73 | 288.06 | 288.06 | 289.37 |
| W, eV | 1.36 | 1.34 | 1.34 | 1.34 | 1.37 | |
| Irel | 0.54 | 0.26 | 0.05 | 0.07 | 0.08 | |
| BCP-Ag | Eb, eV | 285.19 | 286.73 | 288.06 | 288.06 | 289.37 |
| W, eV | 1.30 | 1.30 | 1.30 | 1.30 | 1.30 | |
| Irel | 0.60 | 0.24 | 0.05 | 0.06 | 0.05 |
| Samples | C | O | Ag | Ag/O | О/С | Ag/C |
|---|---|---|---|---|---|---|
| BC | 42.3 | 57.7 | 1.36 | |||
| BCP | 45.5 | 54.5 | 1.2 | |||
| BC-Ag | 47.8 | 17.8 | 34.3 | 1.93 | 0.37 | 0.72 |
| BCP-Ag | 69.8 | 21.2 | 9.0 | 0.42 | 0.30 | 0.13 |
| Eb | SOS | Ek | AP | ||||
|---|---|---|---|---|---|---|---|
| Sample | 3d5/2, eV | 3d3/2, eV | 3d3/2- 3d5/2, eV | M4N45N45, eV | M5N45N45, eV | 3d5/2+ M4N45N45, eV | State |
| Ag | 368.327 | 357.855 | 726.182 | Ag0 [55] | |||
| BC-Ag | 369.0 | 375.0 | 6.0 | 357.1 | 726.1 | Ag0 | |
| BCP-Ag | 368.4 | 374.4 | 6.0 | 355.5 | 349.7 | 723.8 | Agδ+ |
| 369.7 | 375.6 | 5.9 | 357.1 | 351.2 | 726.8 | Ag0 | |
| Sample | Group | C=O | C(O*)O | C-OH | O-C-O | C(O)O* |
|---|---|---|---|---|---|---|
| BC | Eb, eV | 532.1 | 532.8 | 533.4 | 534.0 | |
| W, eV | 1.00 | 0.91 | 0.91 | 1.15 | ||
| Irel | 0.1 | 0.48 | 0.32 | 0.1 | ||
| BCP | Eb, eV | 531.9 | 532.1 | 532.8 | 533.4 | 534.1 |
| W, eV | 1.17 | 1.1 | 1.02 | 1.0 | 1.2 | |
| Irel | 0.13 | 0.1 | 0.4 | 0.27 | 0.1 | |
| BC-Ag | Eb, eV | 531.5 | 532.0 | 532.7 | 533.4 | 534.1 |
| W, eV | 1.0 | 1.1 | 1.13 | 1.14 | 1.17 | |
| Irel | 0.07 | 0.14 | 0.39 | 0.26 | 0.14 | |
| BCP-Ag | Eb, eV | 531.7 | 532.0 | 532.8 | 533.4 | 534.2 |
| W, eV | 1.00 | 1.10 | 1.15 | 1.14 | 1.15 | |
| Irel | 0.06 | 0.14 | 0.40 | 0.26 | 0.14 |
| Sample | Inhibition Zone, mm. | ||||
|---|---|---|---|---|---|
| Bacillus subtilis ATCC 6633 | S. aureus FDA 209 ATCC 6538 | Escherichia coli ATCC 25922. | Aspergillus niger ATCC 16404 | C. albicans ATCC 2091 | |
| BCP | 0 | 0 | 0 | 0 | 0 |
| BC-Ag | 16 ± 0.4 | 0 | 0 | 0 | 0 |
| BCP-Ag | 18 ± 0.3 | 9 ± 0.1 | 0 | 8 ± 0.1 | 0 |
| Amoxicillin 20 µg. | 42 ± 0.7 | 27 ± 0.7 | 29 ± 0.2 | not tested | not tested |
| Amphotericin B 40 µg. | not tested | not tested | not tested | 10 ± 0.4 | 12 ± 0.6 |
Publisher’s Note: MDPI stays neutral with regard to jurisdictional claims in published maps and institutional affiliations. |
© 2022 by the authors. Licensee MDPI, Basel, Switzerland. This article is an open access article distributed under the terms and conditions of the Creative Commons Attribution (CC BY) license (https://creativecommons.org/licenses/by/4.0/).
Share and Cite
Vasil’kov, A.; Budnikov, A.; Gromovykh, T.; Pigaleva, M.; Sadykova, V.; Arkharova, N.; Naumkin, A. Effect of Bacterial Cellulose Plasma Treatment on the Biological Activity of Ag Nanoparticles Deposited Using Magnetron Deposition. Polymers 2022, 14, 3907. https://doi.org/10.3390/polym14183907
Vasil’kov A, Budnikov A, Gromovykh T, Pigaleva M, Sadykova V, Arkharova N, Naumkin A. Effect of Bacterial Cellulose Plasma Treatment on the Biological Activity of Ag Nanoparticles Deposited Using Magnetron Deposition. Polymers. 2022; 14(18):3907. https://doi.org/10.3390/polym14183907
Chicago/Turabian StyleVasil’kov, Alexander, Alexander Budnikov, Tatiana Gromovykh, Marina Pigaleva, Vera Sadykova, Natalia Arkharova, and Alexander Naumkin. 2022. "Effect of Bacterial Cellulose Plasma Treatment on the Biological Activity of Ag Nanoparticles Deposited Using Magnetron Deposition" Polymers 14, no. 18: 3907. https://doi.org/10.3390/polym14183907
APA StyleVasil’kov, A., Budnikov, A., Gromovykh, T., Pigaleva, M., Sadykova, V., Arkharova, N., & Naumkin, A. (2022). Effect of Bacterial Cellulose Plasma Treatment on the Biological Activity of Ag Nanoparticles Deposited Using Magnetron Deposition. Polymers, 14(18), 3907. https://doi.org/10.3390/polym14183907








